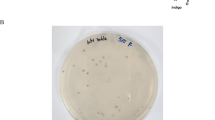

Abstract
Biosurfactants (BSs) are known for their remarkable properties, however, their commercial applications are hampered partly by the high production cost. To overcome this issue, a biosurfactant producing strain, Rhodotorula sp.CC01 was isolated using landfill leachate as nitrogen source, while olive oil was determined as the best sole carbon source. The BS produced by Rhodotorula sp.CC01 had oil displacement diameter of 19.90 ± 0.10 cm and could reduce the surface tension of water to 34.77 ± 0.63 mN/m. It was characterized as glycolipids by thin layer chromatography, FTIR spectra, and GC–MS analysis, with the critical micelle concentration of 70 mg/L. Meanwhile, the BS showed stability over a wide range of pH (2–12), salinity (0–100 g/L), and temperature (20–100 °C). During the cultivation process, BS was produced with a maximum rate of 163.33 mg L−1 h−1 and a maximum yield of 1360 mg/L at 50 h. In addition, the removal efficiency of NH4+–N reached 84.2% after 75 h cultivation with a maximum NH4+–N removal rate of 3.92 mg L−1 h−1. Moreover, Rhodotorula sp.CC01 has proven to be of great potential in remediating petroleum hydrocarbons, as revealed by chromogenic assays. Furthermore, genes related to nitrogen metabolism and glycolipid metabolism were found in this strain CC01 after annotating the genome data with KEGG database, such as narB, glycoprotein glucosyltransferase, acetyl-CoA C-acetyltransferase, LRA1, LRA3, and LRA4. The findings of this study prove a cost-effective strategy for the production of BS by yeast through the utilization of landfill leachate.
Graphical abstract

Similar content being viewed by others
Explore related subjects
Discover the latest articles, news and stories from top researchers in related subjects.Avoid common mistakes on your manuscript.
Introduction
Surfactants are amphiphilic compounds containing both hydrophilic and hydrophobic moieties (Markande et al. 2021; Sun et al. 2019). These moieties can reduce the surface and interfacial tensions and improve the solubility of hydrophobic compounds, thereby increasing the mobility and bioavailability of hydrophobic substrates (Ashitha et al. 2020; Derguine et al. 2021; Junhui Zhang et al. 2018). Surfactants can be synthesized by chemical routes, such as synthetic chemical surfactants, or produced by microorganisms, which are surface-active metabolites known as biosurfactant (BS) (Eldin and Nermeen Hossam 2019). Chemical surfactants tend to cause secondary pollution in soil and water, and pose potential hazards to human health and the environment (Derguine et al. 2021). Compared with chemical surfactants, BSs have more advantages, such as renewability, low toxicity, high biodegradability, and high environmental compatibility (Femina Carolin et al. 2021; Nogueira Felix et al. 2019; Rufino et al. 2011). In fact, surface tension could be reduced at lower concentrations of BS, making them more effective than chemical surfactants (Carolin et al. 2021). Overall, BS is a promising alternative for chemical surfactants (Femina Carolin et al. 2021; Nogueira Felix et al. 2019).
A large number of microorganisms have been reported to be capable of producing BS (Markande et al. 2021), such as Sphingobacterium (Burgos-Diaz et al. 2011), Bacillus (Sharma and Pandey 2020), Pseudomonas (Sun et al. 2019), Paracoccus (Xu et al. 2020), Acinetobacter (Zhou et al. 2020), and Wickerhamomyces anomalus (Teixeira et al. 2018). Due to the high production cost, complicated purification process, and low yield, the mass production of BS is limited (Carolin et al. 2021). A large proportion of BS production cost comes from raw materials, and it is a good strategy to produce BS using waste resources instead of traditional raw materials, which can significantly reduce production costs (Dobler et al. 2020). Microorganisms require suitable carbon and nitrogen sources which are essential for the production and synthesis of BS. (Aparna et al. 2012; Datta et al. 2018; He et al. 2020; Rosas-Galvan et al. 2018). To achieve this, various carbon sources such as molasses, whey, glycerol, orange peelings, coconut oil cake, wastewater from olive oil mills, and crude glycerin were explored. (Aparna et al. 2012; Derguine et al. 2021; Dobler et al. 2020). Meanwhile, desirable nitrogen sources such as residual brewery yeast and urea were also explored for BS production. (Fonseca et al. 2007). However, few studies have worked on reducing the production cost of BS by replacing traditional nitrogen sources with NH4+–N-rich wastewaters, such as landfill leachate.
Landfill leachate is a type of wastewater comprised of rainwater, snow water, and moisture seepage from garbage landfills (Wu et al. 2016). Because of the complex composition, high organic matter and NH4+–N concentrations, landfill leachate poses great threats to ecosystems, including surrounding soils, rivers, groundwater, and the ocean environment (Koc-Jurczyk and Jurczyk 2017; Ren et al. 2017; Wu et al. 2020; Yuan et al. 2019). On the other hand, compared with chemical and physical methods, biological treatment is a better choice for landfill leachate treatments due to the cost-effectiveness, environmental friendliness and feasibility (Yu et al. 2014; Zhang et al. 2020). However, high concentrations of NH4+–N in landfill leachate leads to poor biodegradability and low C/N ratio and presents a great challenge to biological methods (Yu et al. 2014). Owing to the aforementioned problems, the removal of NH4+–N from landfill leachate is necessary. Currently, NH4+–N pretreatment strategies mainly include nitrogen blowing, coagulation, electrocoagulation, oxidation, photocatalysis, and so on (Pirsaheb et al. 2015; Wang et al. 2003; Yu et al. 2014). However, most of these treatments are cost-consuming and can potentially cause secondary pollution (Yu et al. 2014). Using landfill leachate as a nitrogen source to produce BS can be a promising alternative to alleviate the nitrogen pollution.
Besides the landfill leachate problem, many petroleum hydrocarbons leakage occurs every year (Priya et al. 2015). Improper treatments threaten the environment through soil, groundwater, and ocean pollution (Sood and Lal 2009). Biodegradation is a potentially powerful remediation approach to decontaminate oil pollutants since petroleum hydrocarbons exist naturally in the environment, and numerous microorganisms possess ability to utilize them as carbon sources and energy for growth (Yang et al. 2020). To date, studies on the application of BS-producing microorganisms to oil pollution have been extensively reported (Wei et al. 2020; Yang et al. 2020). However, few studies have reported the application of BS produced by Rhodotorula in these processes.
Hence, the main objectives of this study were to: (1) isolate BS-producing yeast using landfill leachate as nitrogen source and characterize the properties of the corresponding BS produced; (2) investigate the effect of the strain on nitrogen removal in landfill leachate; and (3) explore the effect of the strain on petroleum hydrocarbon utilization. This study is the first attempt to produce BS using landfill leachate as the nitrogen source. This could provide insightful information for the development of nitrogen removal strategy from landfill leachate.
Materials and methods
Isolation of BS-producing strain
The landfill leachate used for the isolation of BS-producing strain was collected from Tuan Jishan Island of Zhoushan, China (122°6′4″N, 29°58′15″E). About 1 mL of landfill leachate was added into 200 mL of mineral salt medium (MSM) supplemented with 1% (m/v) olive oil. The compositions of MSM (pH 6.5–7.0) were the same as previously reported (Zhou et al. 2015). The culture was incubated at 30 °C with shaking (180 rpm) for 3 days. Then, the culture suspension was scribed in blood agar plate (Ohadi et al. 2017) and blue agar plate (Sun et al. 2019), and incubated overnight. The isolates, which formed halos around their colonies, were incubated in the MSM with 1% (m/v) olive oil as the sole carbon source. Ultimately, the culture supernatants were collected to evaluate the oil spreading performance and surface tension (ST). Briefly, 200 mL distilled water was added in a petri plate (20 cm), followed by the addition of 400 μL crude oil to the surface of the water (Huang et al. 2020a). Then, 10 μL of cell-free supernatant was added to the center of the oil film, the MSM without inoculum was used as a control. The diameter of the clear zone was measured immediately. For ST measurement, 10 mL of the supernatant was added in a petri dish and analyzed using a tension-meter (BZY 201, Shanghai Fangrui Instrument Co. Ltd, China) at room temperature.
Molecular identification of the isolated yeast
The strain with the best performance was selected for molecular identification. The genomic DNA was obtained using a EasyPure® Genomic DNA Kit (purchased from TransGen Biotech, Beijing, China). The extracted DNA was further subjected to polymerase chain reaction (PCR) with ITS rRNA universal primers of ITS1 (TCCGTAGGTGAACCTGCGG) and ITS4 (TCCTCCGCTTATTGATATGC). The DNA sequence was compared with that of other microorganisms by BLAST. A phylogenetic tree was constructed using MEGA 7.0 software via the neighbour-joining method (Huang et al. 2020a).
Optimization of BS-producing conditions
Eight carbon sources were individually added to MSM (1%, m/v) as the sole carbon source, including yeast extract, sodium acetate, glucose, n-hexadecane, olive oil, glycerol, diesel oil, and paraffin. After 3 days of incubation (30 °C, 180 rpm), the cell-free supernatant was collected by centrifugation at 8000 rpm for 5 min, then further characterized through ST and growth (OD600) evaluations.
Growth, nitrogen removal, and BS production performance of Rhodotorula sp.CC01
The Rhodotorula sp.CC01 activated overnight in yeast extract peptone dextrose medium was inoculated into the fermentation medium (1%, v/v), and cultured at 30 °C and 180 rpm. The compositions of fermentation medium (pH 6.5–7.0) were as follows (g/L): NaCl, 15; KH2PO4, 0.5, K2HPO4, 1; MgSO4, 0.5; KCl, 0.01; olive oil, 10; 10 mL of landfill leachate and 1 mL of trace elements (Zhou et al. 2015). Growth (OD600), ST, BS production, NH4+–N, NO2––N, and NO3––N concentrations of the culture were measured at intervals to evaluate the growth ability, BS production property, and nitrogen removal performance. The BS production under different time periods was measured via anthrone-sulfuric acid method (Cameron et al. 1988; Zhang et al. 2012b). The concentrations of NH4+–N, NO2––N and NO3––N were determined via a fully automatic chemical analyzer (Cleverchem380G, DeChem-Tech. GmbH, Germany) after filtration through 0.22 μm pore size nylon filters (Bkmam, Changde, China). The NH4+–N, NO2−–N, and total inorganic nitrogen removal rates were calculated as follows: (c0 − c1)/c0 × 100%, where c0 is the initial NH4+–N/NO2−–N/ total inorganic nitrogen concentration and c1 is the final concentration (Wang et al. 2021; Zeng et al. 2020). The sum of NH4+–N, NO3+–N, and NO2−–N were defined as total inorganic nitrogen (Lu et al. 2019).
Extraction and performance evaluation of the BS
The BS extraction was performed according to the methods previously described by Zhou et al. (2020). Briefly, the culture broth was centrifuged at 8500 rpm for 5 min to obtain cell-free supernatant. Thereafter, 200 mL ethyl acetate was added to the precipitate. Subsequently, the organic phase was separated and concentrated by evaporation in the rotary vacuum evaporator to obtain the crude BS. For drop-collapse test, 1 mL of the culture supernatant was dyed with 100 μL of 0.003% methylene blue solution, and 50 μL of the mixture was dropped onto parafilm. After 1 min, the droplet collapse was observed. MSM was used as a control. CMC was determined by dissolving the BS in alkaline water (pH 9.0) to prepare a concentration gradient ranging from 2 to 200 mg/L. ST was measured at each concentration until a constant value was reached. CMC was determined by plotting ST as a function of the BS concentration. For stability analysis, the BS solution of 100 mg/L was treated at different temperatures (i.e., 20, 40, 60, 80, and 100 °C), salinity (i.e., 0, 20, 40, 60, 80, and 100 g/L), pH (i.e., 2, 4, 6, 8, 10, and 12). The ST measurements were repeated three times.
Structure analysis of the BS
The structural property of the BS was investigated through thin layer chromatography (TLC), Fourier transform infrared spectrum (FTIR), and gas chromatography–mass spectrometry (GC–MS) analysis. For TLC analysis, BS was dissolved in petroleum ether, and then collected by capillary tube. About 2 μL of solution was spotted on the silica gel plate (Merck, Darmstadt, Germany). The mobile phase of the petroleum ether/ethyl acetate (2:1, v/v) was used to separate the compounds. Iodine, 10% phosphomolybdic acid solution, 0.25% ninhydrin solution, and phenol-ammonium sulfate, were used to detect lipids, phospholipid, peptide, and carbohydrate, respectively. FTIR (IS10, Thermo-Nicolet, America) was used to analyze the surfactant in the spectral region of 4000–400 cm−1 to detect the functional groups in the sample. The composition and structure of fatty acids in BS were analyzed by GC–MS according to the methods as previously reported (Zhou et al. 2020).
2,6-dichlorophenolindophenol (2,6-DCPIP) test
As a redox indicator, 2,6-DCPIP is blue in the oxidation state and colorless in the reduced state. In the degradation process of petroleum hydrocarbons by microorganisms, electrons were provided by petroleum hydrocarbons as electron donor and electrons were received by 2,6-DCPIP as electron acceptor, thereby forming the redox system. (Dvoranová et al. 2015). The Rhodotorula sp.CC01 cultured overnight was centrifuged and resuspended with 0.9% saline solution to remove the medium components. Substrates were used in the experiment are as follows: cyclooctane, n-decane, n-hexadecane, octadecane, phenanthrene, light crude oil, heavy crude oil, and liquid paraffin. Octadecane and phenanthrene was dissolved in petroleum ether to prepare aqueous solution, respectively. The reaction mixture contained approximately 750 μL MSM, 200 μL 2,6-DCPIP solution (37.5 mg/L), 50 μL FeCl3·6H2O solution (150 mg/L), 200 μL cell suspension, and 10 μL sterilized substrate. The reaction was performed in an incubator (30 °C, 180 rpm) for 72 h to observe the color change.
Genome sequencing and annotation
Prior to sequencing, the CC01 cells was harvested through centrifugation for 10 min at 10,000 × g and 4 °C after cultivation for 24 h. Genomic DNA was extracted with a EasyPure® Genomic DNA Kit (purchased from TransGen Biotech, Beijing, China). Whole-genome sequencing was performed on the BGI MGISEQ-2000 platform. Raw data produced by BGI MGISEQ-2000 platform were initially processed to get clean data via filtering adapter reads and low-quality reads. Then, all good quality paired reads were assembled by using the SPAdes (3.14.1 Linux) into a number of scaffolds (141). All assembled transcripts were subjected to one public database KEGG (Kyoto Encyclopedia of Genes and Genomes). A whole genome Blast search were performed against above KEGG database (E-value and minimal alignment length percentage refer to the official website). Then, the complete genome of strain CC01 was uploaded to the NCBI database under the GenBank accession number JAKEZK000000000.
Statistical analysis
The data generated in this study were presented as the mean values of three independent replicates. Microsoft Excel 2010 was used for data processing. Graphs were prepared using Origin 9.1. One-way analysis of variance, Duncan's multiple range test, and Nonparametric statistical test were used to examine the significance of differences (p < 0.05) in the results using SPSS Statistics (Version 20.0, IBM Corp., USA).
Results
Isolation and identification of BS-producing strains
In this study, four strains capable of producing BS were isolated from landfill leachate. Among them, the BS produced by the yeast strain CC01 showed the best performance. The CC01 supernatant exhibited the largest oil displacement diameter (19.90 ± 0.10 cm) and the lowest ST (34.77 ± 0.63 mN/m). Generally, there is a positive correlation between oil spreading diameters and the activity of BS (Zhou et al. 2020). The efficiency of the yeast strain CC01 for the production of BS was confirmed by the reduction in ST (from 71.99 to 34.77 mN/m), a flattened drop, as well as spread oil positive with a displacement zone diameter of 19.9 ± 0.1 cm (Fig. 1b). Morphology of the yeast strain CC01 in LB agar plate was shown in Fig. 1b. The strain was identified as Rhodotorula sp., whose phylogenetic tree was constructed and presented in Fig. 1c. The ITS rRNA gene sequence of CC01 has been submitted to GenBank with an accession number MZ950605.
Drop-collapse test (a), morphological characteristics under plate (b), phylogenetic relationship (c) of strain CC01 isolated from landfill leachate. In Fig. a, right image represents control while left image represents cell-free supernatant. In Fig. c, the tree is constructed using ITS rDNA gene sequence using neighbour-joining method. The strain CC01 was be identified as Rhodotorula sp.
Effect of carbon sources on BS production
BS production is affected by the culture medium, in which carbon, nitrogen, and trace element sources are essential to promote production (Nazareth et al. 2021). Among the eight carbon substrates examined, olive oil (1%, w/v) exhibited significantly better performance than those in other treatments (p < 0.05), with the corresponding ST of the culture medium dropped to 27.66 mN/m (Fig. 2a). Meanwhile, the highest growth of Rhodotorula sp.CC01 was also observed with olive oil as carbon source (OD600 = 2.50), suggesting that the reduction in ST might positively correlated with the cell growth (Fig. 2a).

source for BS production by strain CC01. b Kinetics of growth and ST of strain CC01 during 243 h of incubation. The ST decreased to 28.20 ± 0.51 mN/m at 15 h and remained stable and biomass reached a maximum at 147 h. The error bars represent the standard deviations (n = 3)
a Effects of eight carbon sources on ST and OD600 of strain CC01 after 72 h of incubation. Olive oil was the best carbon
Growth kinetics and BS production of Rhodotorula sp.CC01
After evaluating the optimum carbon source for cultivation, the growth kinetics and BS production (demonstrated by surface tension) were analyzed. As evident from the results displayed, the adaptive phase of Rhodotorula sp.CC01 occurred in the first 39 h, followed by the exponential phase prolonged until 123 h (Fig. 2b). Meanwhile, ST of the culture reduced from 51.87 ± 1.74 to 28.20 ± 0.51 mN/m after 15 h of cultivation during the early exponential and remained stable throughout the incubation period of 243 h.
Nitrogen removal performance and BS production ability of Rhodotorula sp.CC01
The landfill leachate used in this study is rich in nitrogen sources with ammonium concentration as high as 3000 mg/L. Therefore, it was supplemented to the medium as nitrogen sources at the ratio of 1% (m/v) for the production of BS by Rhodotorula sp.CC01. The ability of Rhodotorula sp.CC01 to assimilate different nitrogen sources in the medium was further investigated. It could be observed that with the growth of the strain CC01, a decrease in NH4+–N occurred immediately and 87.5% of NH4+–N was removed in 75 h and the maximum NH4+–N removal rate was 3.92 mg L−1 h−1 (Fig. 3a). Similarly, while NH4+–N was rapidly removed, the removal efficiency of NO2––N reached 71.7% (Fig. 3b). In addition, it is worth noting that significant fluctuations in NO3––N were observed during the process (Fig. 3c), which is probably attributed to heterotrophic nitrification. Finally, the removal efficiency of total inorganic nitrogen reached 80.6% after 75 h cultivation, and strain CC01 proliferated without a lag phase (Fig. 3d), suggesting that nitrogen might be mainly assimilated to organic matter (Civiero et al. 2018). Meanwhile, during the process of nitrogen degradation, the BS was produced with a maximum rate of 163.33 mg L−1 h−1 and a maximum yield of 1360 mg/L at 50 h (Fig. 3e).
The removal performance of NH4+–N (a), NO2−–N (b), NO3−–N (c) and total inorganic nitrogen (d) in landfill leachate by strain CC01 during 75 h cultivation. The BS production and OD600 during 75 h cultivation (e). The removal efficiency of NH4+–N in landfill leachate reached 84.2% after 75 h cultivation. The maximum yield of BS produced by strain CC01 was 1360 mg/L at 50 h. The error bars represent the standard deviations (n = 3)
Properties of produced BS
In this study, the CMC of the BS produced by Rhodotorula sp.CC01 was 70 mg/L and the ST was 33.39 mN/m (Fig. 4a). Meanwhile, the BS exhibited stable surface activity under different pH conditions (p < 0.05) (Fig. 4b). Similarly, the ST of BS had no significant change with salinity ranging from 0 to 100 mg/L (p < 0.05) (Fig. 4c). In addition, the BS also showed excellent stability over a wide temperature range (p < 0.05) (Fig. 4d).
The CMC determination of the BS produced by strain CC01 (a). The CMC of BS was 70 mg/L; The BS stability against different pH (b), salinity (c), and temperature (d). The BS showed excellent stability over a wide pH, salinity, and temperature range. The error bars represent the standard deviations (n = 3)
TLC analysis showed that the BS produced by Rhodotorula sp.CC01 is completely separated using different solvent systems and shows three points (Rf1 = 0.18, Rf2 = 0.70, Rf3 = 0.87) (Fig. 6a). Further chromogenic reaction analysis revealed that the BS contained lipids, peptides, and sugar compounds (Fig. 5a-c), demonstrating that it would be categorized as glycolipoprotein.
TLC (a–c), FTIR spectra (d), and GC–MS (e) analysis of the BS produced by strain CC01. In Fig. a–c, a image represented iodine vapours of color detection. The citric yellow is positive. B image represented the color detection spraying ninhydrin solution to detect peptide content. C image represented the color detection spraying sulfuric acid phenol solution to detect sugar compounds. The BS produced by strain CC01 was classified as glycolipoprotein
FTIR analysis revealed that BS and standard rhamnolipid were fairly similar (Fig. 5d). The primary difference observed in BS and standard rhamnolipid was the bands of 3371 cm−1 (O–H stretch) (Sen et al. 2017). The bands observed at wavenumber 2923 cm−1 and 2853 cm−1 were attributed to the characteristic C–H stretching and vibration, indicating the existence of methyl and methylene groups, respectively (Ashitha et al. 2020; Liu et al. 2014) (Fig. 5d). The peak at 1745 cm−1 corresponded to C=O stretching of lactones and the absorption bands at 1464 cm−1 were caused by C–H stretching and vibration of fatty acid group (Ashitha et al. 2020; Burgos-Diaz et al. 2011; Xiao et al. 2013). The absorption bands observed at 1161 cm−1 demonstrated the existence of C–O and C–O–C bonds of the carboxylic acids, and the bands at 1377 cm−1 revealed the presence of C–N bonds (Derguine et al. 2021; Sen et al. 2017). Above all, FTIR result revealed the presence of aliphatic chains and peptide moieties.
The BS of Rhodotorula sp.CC01 after methyl esterification and hydrolysis was analyzed by GC–MS in order to identify the fatty acid types (Ashitha et al. 2020). Four peaks were observed through GC–MS analysis, which were close to methyl hexadecanoate (C16:0), methyl octadecanoate (C18:0), methyl octadecanoate (C18:1), and methyl octadecanoate (C18:2) (Table 1; Fig. 5e).
Petroleum hydrocarbon utilization range by Rhodotorula sp.CC01
It could be observed that the color of the reaction group containing cyclooctane as the sole carbon source became colorless. This is also the case for other sole carbon sources such as n-decane, n-hexadecane, octacosane, phenanthrene, light crude oil, heavy crude oil, and paraffin, respectively (Fig. 6). Meanwhile, colors of control groups remained blue (Fig. 6). Thus, it could be considered that Rhodotorula sp.CC01 had a wide utilization range of petroleum hydrocarbon including short chain alkanes, medium chain alkanes, long chain alkanes, mixed crude oil, PAHs, and liquid paraffin.
Genomic analysis of the strain CC01
Landfill leachate was utilized as nitrogen source for producing BS by strain CC01 and the BS was identified as glycolipids. In order to investigate the genomic organization of the metabolic pathways responsible for biosynthesis of glycolipids, the complete genome of strain CC01 was sequenced. The principal features of the CC01 genome are shown in Fig. 7a. The total size of genome is 19,972,637 bp with average sequence length of 1,416,499 bp. The Contigs number is 141 and N50 is 342,863 bp. The genome contains 6451 genes, 59.99% average GC content, 47,474 Protein coding genes (CDS), 7 rRNA, and 124 tRNA genes (Table 2). The functions of most genes were associated with important genetic information processing, signaling, cellular processes, and metabolism pathways such as carbohydrate, amino acid, lipid, and energy metabolism and so on (Fig. 7b).
Circular representation of the Rhodotorula sp.CC01 genome (a). The circular map consists of five circles. From the outmost circle inwards, each circle contains information about the genome regarding the tRNA, rRNA, CDS, G + C content (%), and GC skem, respectively. KEGG pathway annotation of assembled genes (b). The genome contains 124 tRNA, 7 rRNA, 47,474 CDS, and 59.99% average GC content. The functions of most genes were associated with important genetic information processing, signaling, cellular processes, and metabolism pathways
Discussion
BSs have attracted extensive attention due to their environmentally-friendliness, biodegradability, biocompatibility, and a wide range of applications in all walks of life (Adnan et al. 2018, 2021). BS-producing strains have been isolated from a variety of sources such as curd (Adnan et al. 2021), Tuja plicata cones (Adnan et al. 2018), fresh rhizosphere samples of healthy planted crops (Eldin et al. 2019), coking wastewater (Sun et al. 2019), oily sludge (Huang et al. 2020a), hydraulic fracturing flowback (Zhou et al. 2020), cold seep sediment (Zhou et al. 2021), and so on. However, the isolation of BS-producing strains from landfill leachate is rarely documented, not to mention the utilization of landfill leachate as low-cost nitrogen source for the cultivation.
In this work, innovative approaches have been developed and applied as strategies to valorize landfill leachate as a nitrogen source for low-cost BS production by the yeast Rhodotorula sp.CC01. The carbon source of the culture medium was optimized and the olive oil showed the best performance (ST = 27.66 mN/m, OD600 = 2.50). A previous study also reported the promotion of BS production by microorganisms cultivated in medium containing olive oil (Huang et al. 2020b). Meanwhile, Teixeira et al. (2018) evaluated BS production by Wickerhamomyces anomalus CCMA 0358 yeast and clarified olive oil as an essential carbon source, which exhibited similar reduction in ST. Derguine et al. (2021) also investigated BS production by Rhodotorula sp. YBR using olive oil mill wastewater as substrate for low-cost production.
Incubation experiment showed that ST reduction was observed after 15 h when growth occurred at the adaptive phase, indicating that the strain can efficiently utilize olive oil and landfill leachate to produce BS in a short time (Fig. 2b). The biomass increased with incubation time and reached a maximum at 147 h, whereas the ST remained steady till the end of the cultivation period. Similar growth-associated production of BS was also observed by Sen et al. (2017). However, Santos et al. (2017) reported that the highest reduction in ST due to BS production by Streptomyces sp. DPUA 1559 was observed after 60 h during the stationary growth.
The results of nitrogen removal analysis showed that the removal efficiency of NH4+–N was 87.5% and the maximum NH4+–N removal rate was 3.92 mg L−1 h−1, which was significantly higher than that of Acinetobacter tandoii MZ-5 (2.28 mg L−1 h−1) (Ouyang et al. 2020), Pseudomonas tolaasii Y-11 (2.04 mg L−1 h−1) (He et al. 2016), and Bacillus methylotrophicus L7 (2.15 mg L−1 h−1) (Zhang et al. 2012a). The removal efficiency of NH4+–N was slightly lower than that of the yeast strain Sporidiobolus pararoseus Y1 (93.42–99.85%) at low ammonium concentration (14.38 ± 0.88 mg/L) and higher than that of the strain Y1 (53.58–74.71%) at ammonium concentration ranging from 72.25 to 141.58 mg/L (Zeng et al. 2020). Similarly, while NH4+–N was rapidly removed, the accumulation of NO3––N was observed for the red yeast Sporidiobolus pararoseus Y1 while NO2––N accumulation was not evident (Zeng et al. 2020).
A positive correlation between BS production and nitrogen removal was observed with a maximum BS production rate and total inorganic nitrogen removal efficiency of 163.33 mg L−1 h−1 and 80.57%, respectively (Fig. 3). Further incubation experiment (51–75 h) showed that the yield of BS decreased from 1360 to 1206 mg/L while the removal efficiency of total inorganic nitrogen and OD600 continued to increase (Fig. 3). It was speculated that during this time period the BS was further utilized as carbon source by the strain for growth (Zeng et al. 2018).
According to the KEGG database, seven genes related to nitrogen metabolism were found, including formamidase, narB, nitrilase, GDH2, gdhA, glnA, and GLT1 (Fig. 7). Some key genes related to glycolipids synthesis were also found, such as glycosyltransferases (glycoprotein glucosyltransferase and mannosyltransferase) and acetyl-CoA C-acetyltransferase (Fig. 7) (Jezierska et al. 2018). Meanwhile, genes related to glycolipids metabolism (LRA1, LRA3, and LRA4) were also found and this further supports the hypothesis that glycolipids serve as carbon sources for growth (Fig. 7) (Yoshiwara et al. 2021).
Generally, the reduction in ST (below 35 mN/m) is one of the critical indicators for distinguishing BS-producing microorganisms (Chandankere et al. 2014). In this study, the CMC (70 mg/L) of the BS produced by Rhodotorula sp.CC01 was much lower than that of literatures (Table 3), indicating higher aggregation ability and better surface activity. (Aparna et al. 2012; Derguine et al. 2021; Huang et al. 2020b; Luna et al. 2013; Marcelino et al. 2019; Sen et al. 2017). Meanwhile, the BS produced by the yeast Rhodotorula sp.CC01 was classified as glycolipoprotein by TLC. Similarly, Derguine et al. (2021) reported that the BS produced by Rhodotorula sp. YBR was characterized as glycolipoprotein, including carbohydrate (Rf = 0.62), protein (Rf = 0.48), and lipid (Rf = 0.76). In addition, the formation of three spots was also observed with Rf = 0.18, 0.70, and 0.87 in the current study, respectively, which is probably due to the presence of other forms of glycolipids, a common phenomenon in the production of sophorolipid by yeasts (Marcelino et al. 2019).
Further FTIR analysis showed that the BS produced by the strain CC01 exhibited similar functional groups with standard rhamnolipid, which are in agreement with those obtained with TLC. The results of FTIR in this study were similar with that of the BS produced by yeast strain Cutaneotrichosporon mucoides UFMG-CM-Y6148 and Cyberlindnera saturnus SBPN-27 (Marcelino et al. 2019; Senthil Balan et al. 2019). For instance, Senthil Balan et al. (2019) reported the existence of glycosidic linkage group at 1109, 1649, 1712, and 1735 cm−1 (1161 and 1745 cm−1 in this study) revealed the conjugation between the sugar molecules and sugar component with the fatty acid molecule. Marcelino et al. (2019) reported a typical band with low intensity around 3001 cm−1 noted the presence of unsaturation between carbons (2923 cm−1 in this study). Moreover, the BS of Rhodotorula sp.CC01 comprise mainly hexa- and octa-decenoic acid by GC–MS analysis which is similar with the BS of Serratia marcescens ZCF25 (Huang et al. 2020b).
Conclusion
This study reported the isolation and identification of an indigenous BS-producing yeast strain from landfill leachate. The strain Rhodotorula sp.CC01 produced BS using landfill leachate as the sole nitrogen source and olive oil as the sole carbon source with the BS yield of 1360 mg/L. In BS producing process, the removal efficiency of NH4+–N reached 84.2% after 75 h cultivation with a maximum NH4+–N removal rate of 3.92 mg L−1 h−1. The BS was characterized as glycolipids and showed stability over a wide range of pH (2–12), salinity (0–100 g/L), and temperature (20–100 °C). Meanwhile, Rhodotorula sp.CC01 exhibits a broad utilization spectrum of petroleum hydrocarbons, suggesting a promising prospect in the remediation of petroleum hydrocarbon pollutants. Further genomic results showed that the strain had seven genes related to nitrogen metabolism such as narB and several genes related to glycolipids metabolism, such as glycoprotein glucosyltransferase, acetyl-CoA C-acetyltransferase, LRA1, LRA3, and LRA4. Overall, the findings in this study opens new future prospects for BS produced at lower costs as an alternative to chemical surfactants and nitrogen removal from landfill leachate.
References
Adnan M, Alshammari E, Ashraf SA, Patel K, Lad K, Patel M (2018) Physiological and molecular characterization of biosurfactant producing endophytic fungi Xylaria regalis from the cones of Thuja plicata as a potent plant growth promoter with its potential application. Biomed Res Int 2018:7362148
Adnan M, Siddiqui AJ, Hamadou WS, Ashraf SA, Hassan MI, Snoussi M, Badraoui R, Jamal A, Bardakci F, Awadelkareem AM, Sachidanandan M, Patel M (2021) Functional and structural characterization of pediococcus pentosaceus-derived biosurfactant and its biomedical potential against bacterial adhesion, quorum sensing, and biofilm formation. Antibiotics (Basel) 10(11):1371
Aparna A, Srinikethan G, Smitha H (2012) Production and characterization of biosurfactant produced by a novel Pseudomonas sp. 2B. Colloids Surf B Biointerfaces 95:23–29
Ashitha A, Radhakrishnan EK, Mathew J (2020) Characterization of biosurfactant produced by the endophyte Burkholderia sp. WYAT7 and evaluation of its antibacterial and antibiofilm potentials. J Biotechnol 313:1–10
Burgos-Diaz C, Pons R, Espuny MJ, Aranda FJ, Teruel JA, Manresa A, Ortiz A, Marques AM (2011) Isolation and partial characterization of a biosurfactant mixture produced by Sphingobacterium sp. isolated from soil. J Colloid Interface Sci 361(1):195–204
Cameron DR, Cooper DG, Neufeld RJJA, Microbiology E (1988) The mannoprotein of Saccharomyces cerevisiae is an effective bioemulsifier. Appl Environ Microbiol 54(6):1420
Carolin CF, Kumar PS, Ngueagni PT (2021) A review on new aspects of lipopeptide biosurfactant: types, production, properties and its application in the bioremediation process. J Hazard Mater 407:124827
Chandankere R, Yao J, Cai M, Masakorala K, Jain AK, Choi MMF (2014) Properties and characterization of biosurfactant in crude oil biodegradation by bacterium Bacillus methylotrophicus USTBa. Fuel 122:140–148
Civiero E, Pintus M, Ruggeri C, Tamburini E, Sollai F, Sanjust E, Zucca P (2018) Physiological and phylogenetic characterization of Rhodotorula diobovata DSBCA06, a Nitrophilous yeast. Biology (Basel), 7(3).
Datta P, Tiwari P, Pandey LM (2018) Isolation and characterization of biosurfactant producing and oil degrading Bacillus subtilis MG495086 from formation water of Assam oil reservoir and its suitability for enhanced oil recovery. Bioresour Technol 270:439–448
Derguine L, Kebbouche S, Djenane D (2021) Biosurfactant production from newly isolated Rhodotorula sp. YBR and its great potential in enhanced removal of hydrocarbons from contaminated soils. World J Microbiol Biotechnol 37(1):18
Dobler L, Ferraz HC, Araujo de Castilho LV, Sangenito LS, Pasqualino IP, Souza Dos Santos AL, Neves BC, Oliveira RR, Guimaraes Freire DM, Almeida RV (2020) Environmentally friendly rhamnolipid production for petroleum remediation. Chemosphere 252:126349
Dvoranová D, Barbieriková Z, Dorotíková S, Malček M, Brincko A, Rišpanová L, Bučinský L, Staško A, Brezová V, Rapta P (2015) Redox processes of 2,6-dichlorophenolindophenolate in different solvents. A combined electrochemical, spectroelectrochemical, photochemical, and theoretical study. J Solid State Electrochem 19(9):2633–2642
Eldin AM, Z.K., Nermeen Hossam. (2019) Isolation and genetic identification of yeast producing biosurfactants, evaluated by different screening methods. Microchem J 146:309–314
Eldin AM, Kamel Z, Hossam N (2019) Isolation and genetic identification of yeast producing biosurfactants, evaluated by different screening methods. Microchem J 146:309–314
Femina Carolin C, Kumar PS, Joshiba GJ, Madhesh P, Ramamurthy R (2021) Sustainable strategy for the enhancement of hazardous aromatic amine degradation using lipopeptide biosurfactant isolated from Brevibacterium casei. J Hazard Mater 408:124943
Fonseca RR, Silva AJR, De França FP, Cardoso VL, Sérvulo EFC (2007) Optimizing carbon/nitrogen ratio for biosurfactant production by a Bacillus subtilis strain. Appl Biochem Biotechnol 137(1):471–486
He T, Li Z, Sun Q, Xu Y, Ye Q (2016) Heterotrophic nitrification and aerobic denitrification by Pseudomonas tolaasii Y-11 without nitrite accumulation during nitrogen conversion. Bioresour Technol 200:493–499
He S, Ni Y, Lu L, Chai Q, Yu T, Shen Z, Yang C (2020) Simultaneous degradation of n-hexane and production of biosurfactants by Pseudomonas sp. strain NEE2 isolated from oil-contaminated soils. Chemosphere 242:125237
Huang X, Zhou H, Ni Q, Dai C, Chen C, Li Y, Zhang C (2020) Biosurfactant-facilitated biodegradation of hydrophobic organic compounds in hydraulic fracturing flowback wastewater: a dose–effect analysis. Environ Technol Innov 19:100889
Huang Y, Zhou H, Zheng G, Li Y, Xie Q, You S, Zhang C (2020b) Isolation and characterization of biosurfactant-producing Serratia marcescens ZCF25 from oil sludge and application to bioremediation. Environ Sci Pollut Res Int 27(22):27762–27772
Jezierska S, Claus S, Van Bogaert I (2018) Yeast glycolipid biosurfactants. FEBS Lett 592(8):1312–1329
Junhui Zhang HL, Gao H, Shibin Hu, Xue Q (2018) Prevention and mitigation of paraffin deposition by biosurfactant-producing and paraffin-degrading Bacillus amyloliquefaciens strain 6–2c. Chem Eng J 335:510–519
Koc-Jurczyk J, Jurczyk L (2017) Biological treatment of landfill leachate at elevated temperature in the presence of polyurethane foam of various porosity. Clean-Soil Air Water 45(3):1500264
Liu H, Wang H, Chen X, Liu N, Bao S (2014) Biosurfactant-producing strains in enhancing solubilization and biodegradation of petroleum hydrocarbons in groundwater. Environ Monit Assess 186(7):4581–4589
Lu LL, Wang BJ, Zhang Y, Xia LJ, An D, Li HJ (2019) Identification and nitrogen removal characteristics of Thauera sp. FDN-01 and application in sequencing batch biofilm reactor. Sci Total Environ 690:61–69
Luna JM, Rufino RD, Sarubbo LA, Campos-Takaki GM (2013) Characterisation, surface properties and biological activity of a biosurfactant produced from industrial waste by Candida sphaerica UCP0995 for application in the petroleum industry. Colloids Surf B Biointerfaces 102:202–209
Marcelino PRF, Peres GFD, Terán-Hilares R, Pagnocca FC, Rosa CA, Lacerda TM, dos Santos JC, da Silva SS (2019) Biosurfactants production by yeasts using sugarcane bagasse hemicellulosic hydrolysate as new sustainable alternative for lignocellulosic biorefineries. Ind Crops Prod 129:212–223
Markande AR, Patel D, Varjani S (2021) A review on biosurfactants: properties, applications and current developments. Bioresour Technol 330:124963
Nazareth TC, Zanutto CP, Maass D, de Souza AAU, de Guelli Ulson de Souza SMDA (2021) Bioconversion of low-cost brewery waste to biosurfactant: an improvement of surfactin production by culture medium optimization. Biochem Eng J 172:108058
Nogueira Felix AK, Martins JJL, Lima Almeida JG, Giro MEA, Cavalcante KF, Maciel Melo VM, Loiola Pessoa OD, Ponte Rocha MV, Rocha Barros Goncalves L, Saraiva de Santiago Aguiar R (2019) Purification and characterization of a biosurfactant produced by Bacillus subtilis in cashew apple juice and its application in the remediation of oil-contaminated soil. Colloids Surf B Biointerfaces 175:256–263
Ohadi M, Dehghannoudeh G, Shakibaie M, Banat IM, Pournamdari M, Forootanfar H (2017) Isolation, characterization, and optimization of biosurfactant production by an oil-degrading Acinetobacter junii B6 isolated from an Iranian oil excavation site. Biocatal Agric Biotechnol 12:1–9
Ouyang L, Wang K, Liu X, Wong MH, Hu Z, Chen H, Yang X, Li S (2020) A study on the nitrogen removal efficacy of bacterium Acinetobacter tandoii MZ-5 from a contaminated river of Shenzhen, Guangdong Province, China. Bioresour Technol 315:123888
Pirsaheb M, Azizi E, Almasi A, Soltanian M, Khosravi T, Ghayebzadeh M, Sharafi K (2015) Evaluating the efficiency of electrochemical process in removing COD and NH4–N from landfill leachate. Desalin Water Treat 57(15):6644–6651
Priya A, Mandal AK, Ball AS, Manefield M, Lal B, Sarma PM (2015) Mass culture strategy for bacterial yeast co-culture for degradation of petroleum hydrocarbons in marine environment. Mar Pollut Bull 100(1):191–199
Ren Y, Ferraz F, Kang AJ, Yuan Q (2017) Treatment of old landfill leachate with high ammonium content using aerobic granular sludge. J Biol Eng 11:42
Rosas-Galvan NS, Martinez-Morales F, Marquina-Bahena S, Tinoco-Valencia R, Serrano-Carreon L, Bertrand B, Leon-Rodriguez R, Guzman-Aparicio J, Alvarez-Berber L, Trejo-Hernandez MR (2018) Improved production, purification, and characterization of biosurfactants produced by Serratia marcescens SM3 and its isogenic SMRG-5 strain. Biotechnol Appl Biochem 65(5):690–700
Rufino RD, Luna JM, Sarubbo LA, Rodrigues LR, Teixeira JA, Campos-Takaki GM (2011) Antimicrobial and anti-adhesive potential of a biosurfactant Rufisan produced by Candida lipolytica UCP 0988. Colloids Surf B Biointerfaces 84(1):1–5
Santos APP, Silva MDS, Costa EVL, Rufino RD, Santos VA, Ramos CS, Sarubbo LA, Porto ALF (2017) Production and characterization of a biosurfactant produced by Streptomyces sp. DPUA 1559 isolated from lichens of the Amazon region. Braz J Med Biol Res 51(2):e6657
Sen S, Borah SN, Bora A, Deka S (2017) Production, characterization, and antifungal activity of a biosurfactant produced by Rhodotorula babjevae YS3. Microb Cell Fact 16(1):95
Senthil Balan S, Ganesh Kumar C, Jayalakshmi S (2019) Physicochemical, structural and biological evaluation of Cybersan (trigalactomargarate), a new glycolipid biosurfactant produced by a marine yeast, Cyberlindnera saturnus strain SBPN-27. Process Biochem 80:171–180
Sharma S, Pandey LM (2020) Production of biosurfactant by Bacillus subtilis RSL-2 isolated from sludge and biosurfactant mediated degradation of oil. Bioresour Technol 307:123261
Sood N, Lal B (2009) Isolation of a novel yeast strain Candida digboiensis TERI ASN6 capable of degrading petroleum hydrocarbons in acidic conditions. J Environ Manag 90(5):1728–1736
Sun S, Wang Y, Zang T, Wei J, Wu H, Wei C, Qiu G, Li F (2019) A biosurfactant-producing Pseudomonas aeruginosa S5 isolated from coking wastewater and its application for bioremediation of polycyclic aromatic hydrocarbons. Bioresour Technol 281:421–428
Teixeira KS, Gudina EJ, Schwan RF, Rodrigues LR, Dias DR, Teixeira JA (2018) Improvement of biosurfactant production by Wickerhamomyces anomalus CCMA 0358 and its potential application in bioremediation. J Hazard Mater 346:152–158
Wang F, Smith DW, El-Din MG (2003) Application of advanced oxidation methods for landfill leachate treatment—a review. J Environ Eng Sci 2(6):413–427
Wang R, Xu Q, Chen C, Li X, Zhang C, Zhang D (2021) Microbial nitrogen removal in synthetic aquaculture wastewater by fixed-bed baffled reactors packed with different biofilm carrier materials. Bioresour Technol 331:125045
Wei Z, Wang JJ, Meng Y, Li J, Gaston LA, Fultz LM, DeLaune RD (2020) Potential use of biochar and rhamnolipid biosurfactant for remediation of crude oil-contaminated coastal wetland soil: ecotoxicity assessment. Chemosphere 253:126617
Wu L, Zhang LY, Xu YY, Liang CZ, Kong H, Shi X, Peng YZ (2016) Advanced nitrogen removal using bio-refractory organics as carbon source for biological treatment of landfill leachate. Sep Purif Technol 170:306–313
Wu C, Chen W, Gu Z, Li Q (2020) A review of the characteristics of Fenton and ozonation systems in landfill leachate treatment. Sci Total Environ 762:143131
Xiao B, Yang D-Y, Shi R-J, Zhang Y, Zhang Y, Hao J-S, Li G-Q, Zhao J-Y (2013) Screening of an efficient biosurfactant-producing bacterial strain and the structure and property of its surface-active metabolic product. Shengtaixue Zazhi 32(3):779–786
Xu M, Fu X, Gao Y, Duan L, Xu C, Sun W, Li Y, Meng X, Xiao X (2020) Characterization of a biosurfactant-producing bacteria isolated from Marine environment: surface activity, chemical characterization and biodegradation. J Environ Chem Eng 8(5):104277
Yang Z, Hollebone BP, Shah K, Yang C, Brown CE, Dodard S, Sarrazin M, Sunahara G (2020) Biodegradation potential assessment by using autochthonous microorganisms from the sediments from Lac Megantic (Quebec, Canada) contaminated with light residual oil. Chemosphere 239:124796
Yoshiwara K, Watanabe S, Watanabe Y (2021) Crystal structure of l-rhamnose 1-dehydrogenase involved in the nonphosphorylative pathway of l-rhamnose metabolism in bacteria. FEBS Lett 595(5):637–646
Yu D, Yang J, Teng F, Feng L, Fang X, Ren H (2014) Bioaugmentation treatment of mature landfill leachate by new isolated ammonia nitrogen and humic acid resistant microorganism. J Microbiol Biotechnol 24(7):987–997
Yuan CL, Lu CH, Ma YG, Wang YZ, Xie YH, Zhang K, Wang YQ, Lv LT, Feng XL, Zhu T (2019) A novel method to treat old landfill leachate combining multi-stage biological contact oxidation (MBCO) and single-stage autotrophic nitrogen removal using anammox and partial nitrification (SNAP). Chem Eng J 359:1635–1643
Zeng Z, Liu Y, Zhong H, Xiao R, Zeng G, Liu Z, Cheng M, Lai C, Zhang C, Liu G, Qin L (2018) Mechanisms for rhamnolipids-mediated biodegradation of hydrophobic organic compounds. Sci Total Environ 634:1–11
Zeng J, Liao S, Qiu M, Chen M, Ye J, Zeng J, Wang A (2020) Effects of carbon sources on the removal of ammonium, nitrite and nitrate nitrogen by the red yeast Sporidiobolus pararoseus Y1. Bioresour Technol 312:123593
Zhang QL, Liu Y, Ai GM, Miao LL, Zheng HY, Liu ZP (2012a) The characteristics of a novel heterotrophic nitrification-aerobic denitrification bacterium, Bacillus methylotrophicus strain L7. Bioresour Technol 108:35–44
Zhang F, Li X, Wang Z, Jiang H, Ren S, Peng Y (2020) Simultaneous Ammonium oxidation denitrifying (SAD) in an innovative three-stage process for energy-efficient mature landfill leachate treatment with external sludge reduction. Water Res 169:115156
Zhang X, Zhang Y, Dai C, Xu D (2012b) Comparison of three methods of measuring rhamnolipids using sugar development process. 19(1):31–41
Zhou H, Chen J, Yang Z, Qin B, Li Y, Kong X (2015) Biosurfactant production and characterization of Bacillus sp. ZG0427 isolated from oil-contaminated soil. Ann Microbiol 65(4):2255–2264
Zhou H, Huang X, Liang Y, Li Y, Xie Q, Zhang C, You S (2020) Enhanced bioremediation of hydraulic fracturing flowback and produced water using an indigenous biosurfactant-producing bacteria Acinetobacter sp. Y2. Chem Eng J 397:125348
Zhou H, Jiang L, Li K, Chen C, Lin X, Zhang C, Xie Q (2021) Enhanced bioremediation of diesel oil-contaminated seawater by a biochar-immobilized biosurfactant-producing bacteria Vibrio sp. LQ2 isolated from cold seep sediment. Sci Total Environ 793:148529
Acknowledgements
This study was financially supported by Zhoushan Science and Technology Department Project (Grant No. 2019C81056), the National Natural Science Foundation of China (Grant Nos. 51978189; 52070050), and by the Research Funds of the Guangxi Key Laboratory of Theory and technology for Environmental Pollution Control (Grant No. 2001K004).
Author information
Authors and Affiliations
Contributions
XL: Conceptualization, Methodology, Investigation, Formal analysis, Data curation, Writing—original draft; HZ: Investigation, Formal analysis, Data curation; FZ: Investigation; LJ: Investigation; EOA: Manuscript revision; GC: Data curation; CZ: Validation, Writing—review and editing, Project administration; QX: Review and editing.
Corresponding authors
Ethics declarations
Conflict of interest
The authors declare that they have no known competing financial interests or personal relationships that could have appeared to influence the work reported in this paper.
Additional information
Publisher's Note
Springer Nature remains neutral with regard to jurisdictional claims in published maps and institutional affiliations.
Rights and permissions
About this article
Cite this article
Lin, X., Zhou, H., Zeng, F. et al. A biosurfactant-producing yeast Rhodotorula sp.CC01 utilizing landfill leachate as nitrogen source and its broad degradation spectra of petroleum hydrocarbons. World J Microbiol Biotechnol 38, 68 (2022). https://doi.org/10.1007/s11274-022-03254-z
Received:
Accepted:
Published:
DOI: https://doi.org/10.1007/s11274-022-03254-z